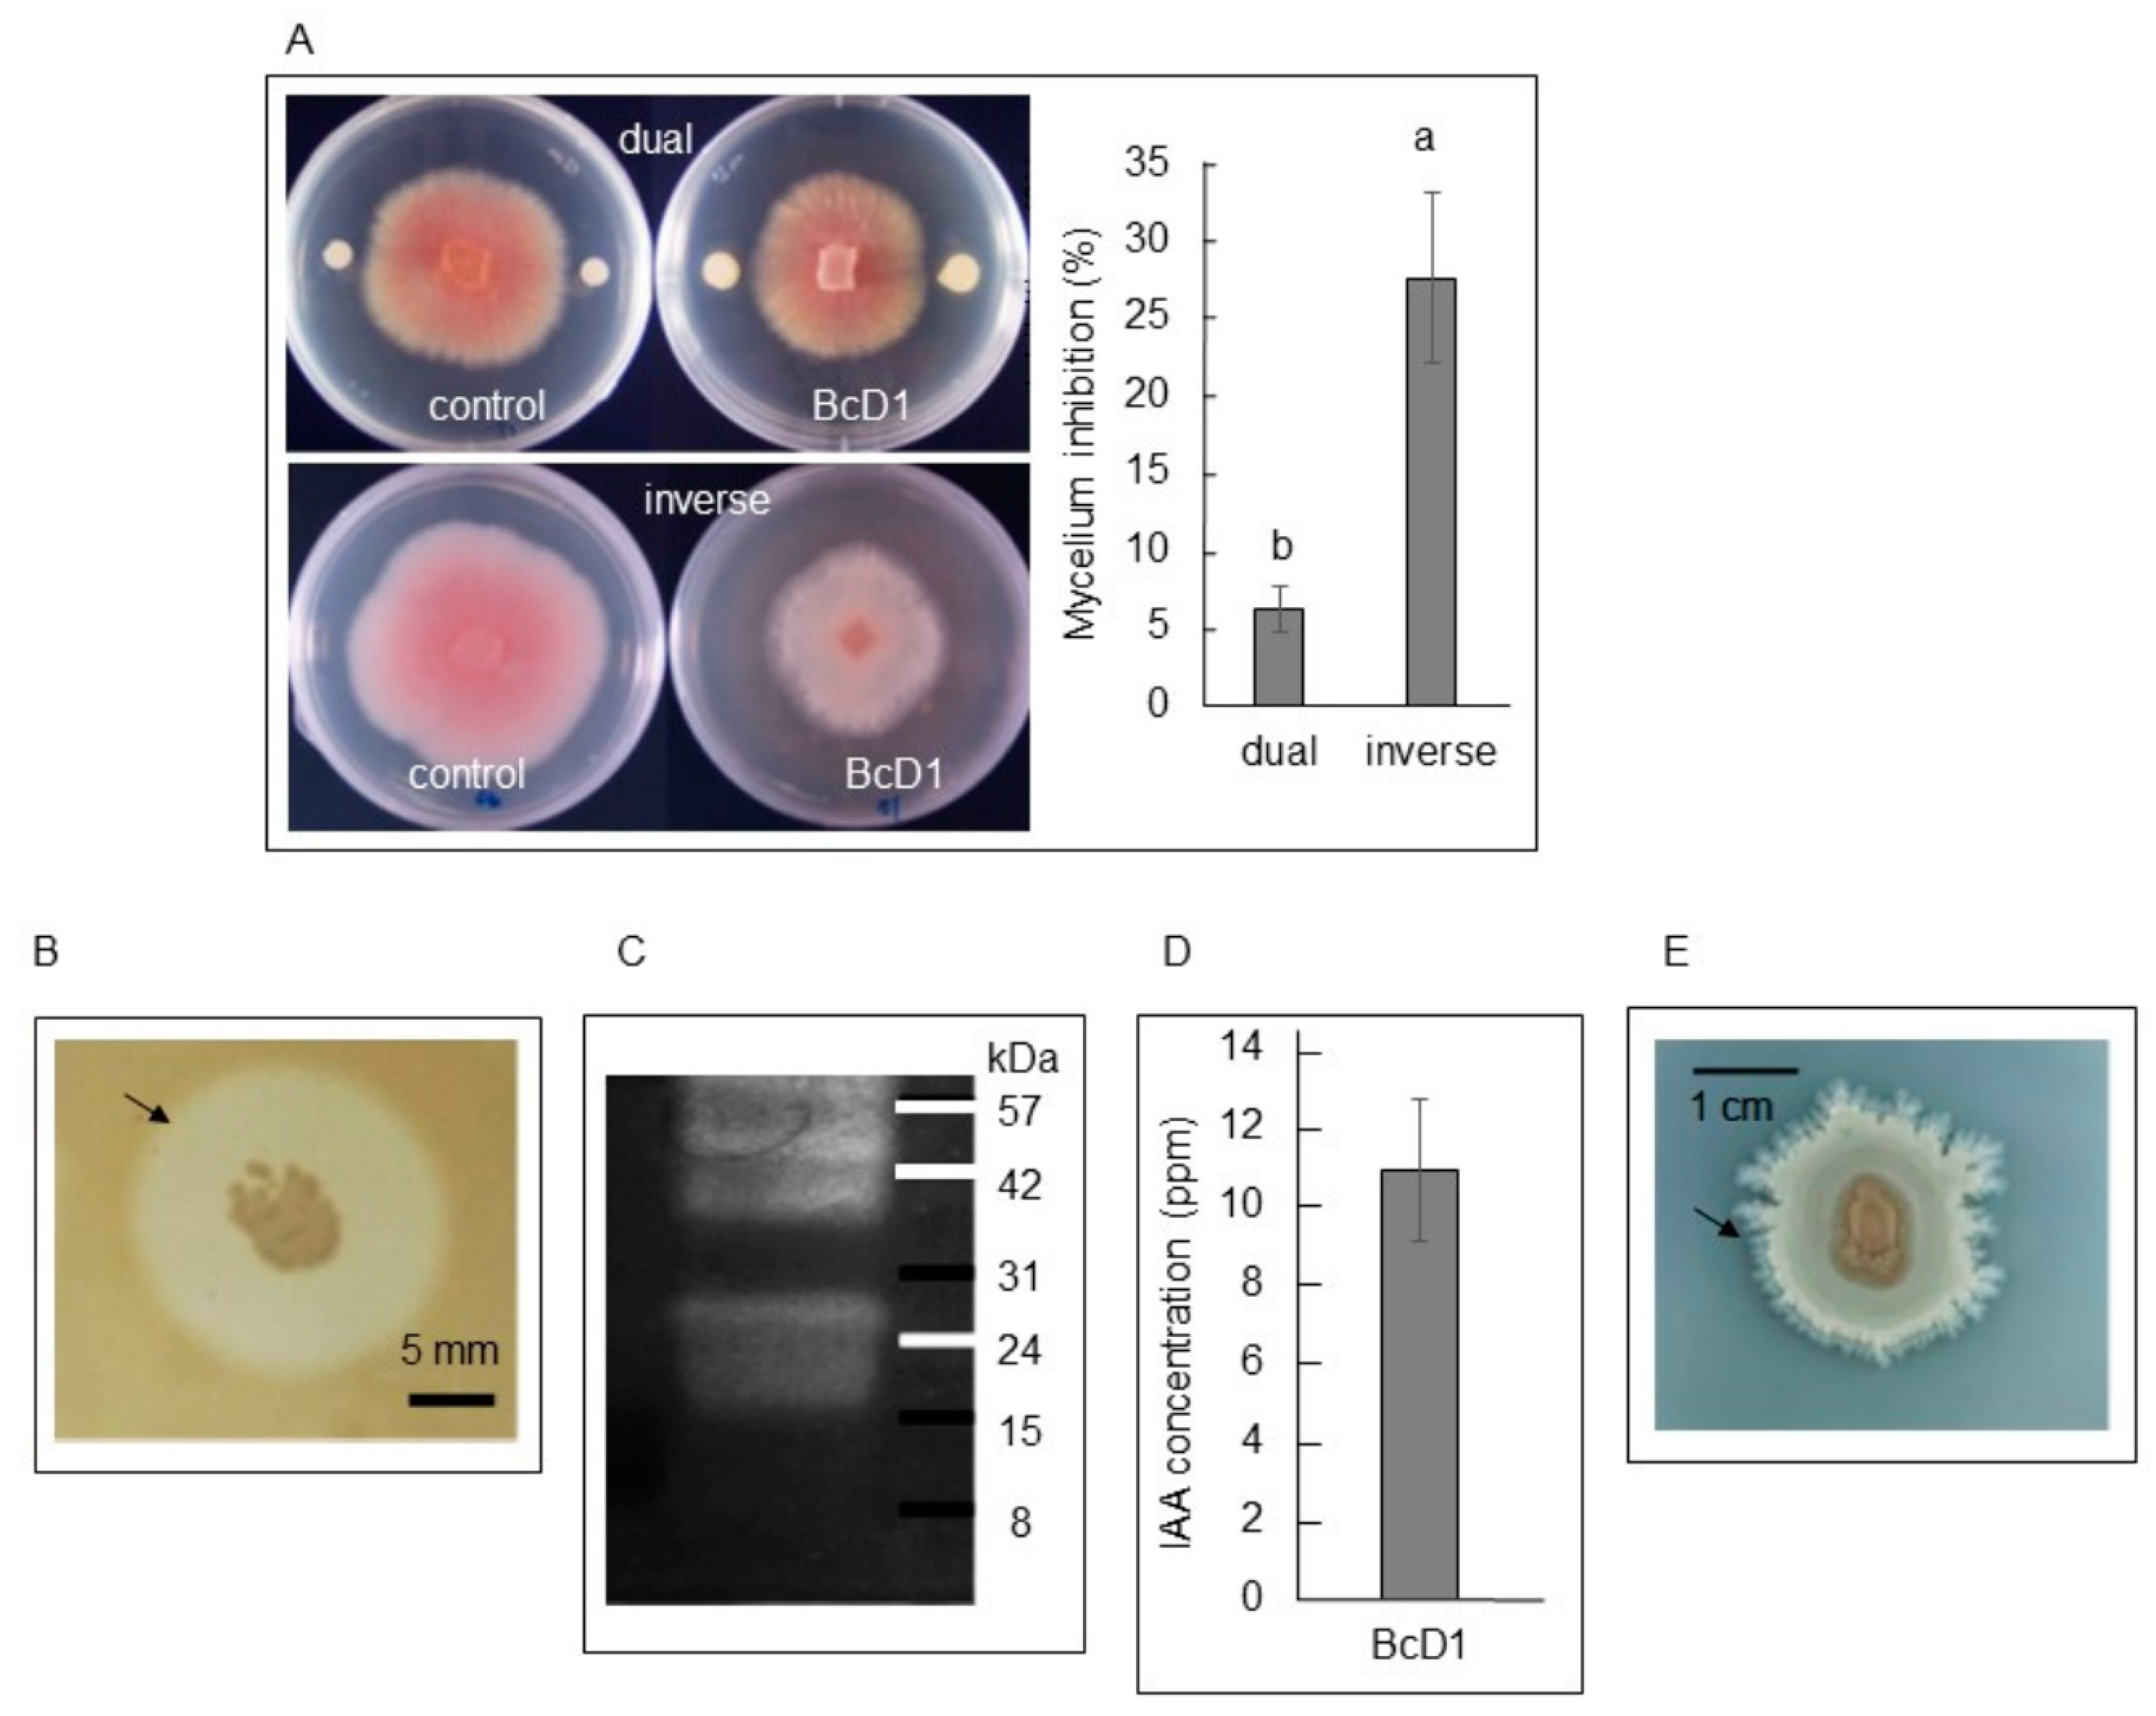
Metabolites 13 00676 g002

Exploring the Biologically Active Metabolites Produced by Bacillus cereus for Plant Growth Promotion, Heat Stress Tolerance, and Resistance to Bacterial Soft Rot in Arabidopsis
Abstract
1. Introduction
2. Materials and Methods
2.1. Isolation, Identification and Characterization of BcD1
2.1.1. De Novo Whole Genome Assembly
2.1.2. Antifungal Activity
2.1.3. Protease Activity
2.1.4. Quantitation of IAA and Phosphate Solubility
2.2. Plant Experiments
2.2.1. Growth Promoting
2.2.2. Lignin, Glucosinolate, Triterpene, Flavonoid, and Total Phenolic Content
2.2.3. Antioxidant Activity
2.2.4. Effect on Stress Tolerance
2.2.5. RNA-seq Analysis
2.2.6. qPCR Analysis
2.3. Statistics
3. Results and Discussion
3.1. Isolation, Identification and Characterization of BcD1
3.1.1. De Novo Whole-Genome Assembly
3.1.2. Antifungal Activity
3.1.3. Protease Activity
3.1.4. IAA Production and Phosphate Solubility
3.2. Plant Experiments
3.2.1. Growth Promoting
3.2.2. Lignin, Glucosinolate, Triterpene, Flavonoid, and Total Phenolic Content
3.2.3. Antioxidant Activity
3.2.4. Effect on Stress Tolerance
3.2.5. RNA-seq Analysis
3.2.6. qPCR Analysis
4. Conclusions
Author Contributions
Funding
Institutional Review Board Statement
Informed Consent Statement
Data Availability Statement
Conflicts of Interest
References
- Lucke, M.; Correa, M.G.; Levy, A. The Role of Secretion Systems, Effectors, and Secondary Metabolites of Beneficial Rhizobacteria in Interactions with Plants and Microbes. Front. Plant Sci. 2020, 11, 589416. [Google Scholar] [CrossRef] [PubMed]
- Van Puyvelde, S.; Cloots, L.; Engelen, K.; Das, F.; Marchal, K.; Vanderleyden, J.; Spaepen, S. Transcriptome analysis of the rhizosphere bacterium Azospirillum brasilense reveals an extensive auxin response. Microb. Ecol. 2011, 61, 723–728. [Google Scholar] [CrossRef] [PubMed]
- Ahmed, A.; Hasnain, S. Auxin-producing Bacillus sp.: Auxin quantification and effect on the growth of Solanum tuberosum. Pure Appl. Chem. 2010, 82, 313–319. [Google Scholar] [CrossRef]
- Kaur, J.; Mudgal, G.; Chand, K.; Singh, G.B.; Perveen, K.; Bukhari, N.A.; Debnath, S.; Mohan, T.C.; Charukesi, R.; Singh, G. An exopolysaccharide-producing novel Agrobacterium pusense strain JAS1 isolated from snake plant enhances plant growth and soil water retention. Sci. Rep. 2022, 12, 21330. [Google Scholar] [CrossRef] [PubMed]
- Ilyas, N.; Mumtaz, K.; Akhtar, N.; Yasmin, H.; Sayyed, R.Z.; Khan, W.; El Enshasy, H.A.; Dailin, D.J.; Elsayed, E.A.; Ali, Z. Exopolysaccharides Producing Bacteria for the Amelioration of Drought Stress in Wheat. Sustainability 2020, 12, 8876. [Google Scholar] [CrossRef]
- Kasotia, A.; Varma, A.; Tuteja, N.; Choudhary, D.K. Amelioration of soybean plant from saline-induced condition by exopolysaccharide producing Pseudomonas-mediated expression of high affinity K+-transporter (HKT1) gene. Curr. Sci. 2016, 12, 1961–1967. [Google Scholar] [CrossRef]
- Zhou, C.; Ma, Z.; Zhu, L.; Xiao, Z.; Xie, Y.; Zhu, J.; Wang, J. Rhizobacterial strain Bacillus megaterium bofc15 induces cellular polyamine changes that improve plant growth and drought resistance. Int. J. Mol. Sci. 2016, 17, 976. [Google Scholar] [CrossRef]
- Saha, M.; Sarkar, S.; Sarkar, B.; Sharma, B.K.; Bhattacharjee, S.; Tribedi, P. Microbial siderophores and their potential applications: A review. Environ. Sci. Pollut. Res. Int. 2016, 23, 3984–3999. [Google Scholar] [CrossRef]
- Chakraborty, K.; Kizhakkekalam, V.K.; Joy, M.; Chakraborty, R.D. Bacillibactin class of siderophore antibiotics from a marine symbiotic Bacillus as promising antibacterial agents. Appl. Microbiol. Biotechnol. 2022, 106, 329–340. [Google Scholar] [CrossRef]
- Raaijmakers, J.M.; Mazzola, M. Diversity and natural functions of antibiotics produced by beneficial and plant pathogenic bacteria. Annu. Rev. Phytopathol. 2012, 50, 403–424. [Google Scholar] [CrossRef]
- D’aes, J.; Hua, G.K.H.; De Maeyer, K.; Pannecoucque, J.; Forrez, I.; Ongena, M.; Dietrich, L.E.P.; Thomashow, L.S.; Mavrodi, D.V.; Höfte, M. Biological control of rhizoctonia root rot on bean by phenazine and cyclic lipopeptide-producing Pseudomonas CMR12a. Phytopathology 2011, 101, 996–1004. [Google Scholar] [CrossRef] [PubMed]
- Almario, J.; Bruto, M.; Vacheron, J.; Prigent-Combaret, C.; Moënne-Loccoz, Y.; Muller, D. Distribution of 2,4-Diacetylphloroglucinol Biosynthetic Genes among the Pseudomonas spp. Reveals Unexpected Polyphyletism. Front. Microbiol. 2017, 8, 1218. [Google Scholar] [CrossRef] [PubMed]
- Yi, H.-S.; Ahn, Y.-R.; Song, G.C.; Ghim, S.-Y.; Lee, S.; Lee, G.; Ryu, C.-M. Impact of a bacterial volatile 2, 3-butanediol on Bacillus subtilis rhizosphere robustness. Front. Microbiol. 2016, 7, 993. [Google Scholar] [CrossRef]
- Tyagi, S.; Lee, K.J.; Shukla, P.; Chae, J.C. Dimethyl disulfide exerts antifungal activity against Sclerotinia minor by damaging its membrane and induces systemic resistance in host plants. Sci. Rep. 2020, 10, 6547. [Google Scholar] [CrossRef] [PubMed]
- Kong, H.G.; Shin, T.S.; Kim, T.H.; Ryu, C.M. Stereoisomers of the Bacterial Volatile Compound 2,3-Butanediol Differently Elicit Systemic Defense Responses of Pepper against Multiple Viruses in the Field. Front. Plant Sci. 2018, 9, 90. [Google Scholar] [CrossRef] [PubMed]
- Cappellari, L.d.R.; Chiappero, J.; Palermo, T.B.; Giordano, W.; Banchio, E. Volatile organic compounds from rhizobacteria increase the biosynthesis of secondary metabolites and improve the antioxidant status in Mentha piperita L. grown under salt stress. Agronomy 2020, 10, 1094. [Google Scholar] [CrossRef]
- Gross, A.; Lin, Y.; Weber, P.K.; Pett-Ridge, J.; Silver, W.L. The role of soil redox conditions in microbial phosphorus cycling in humid tropical forests. Ecology 2020, 101, e02928. [Google Scholar] [CrossRef]
- Honma, M.; Shimomura, T. Metabolism of 1-aminocyclopropane-1-carboxylic acid. Agric. Biol. Chem. 1978, 42, 1825–1831. [Google Scholar] [CrossRef]
- Naing, A.H.; Maung, T.T.; Kim, C.K. The ACC deaminase-producing plant growth-promoting bacteria: Influences of bacterial strains and ACC deaminase activities in plant tolerance to abiotic stress. Physiol. Plant. 2021, 173, 1992–2012. [Google Scholar] [CrossRef]
- Ling, L.; Cheng, W.; Jiang, K.; Jiao, Z.; Luo, H.; Yang, C.; Pang, M.; Lu, L. The antifungal activity of a serine protease and the enzyme production of characteristics of Bacillus licheniformis TG116. Arch. Microbiol. 2022, 4, 601. [Google Scholar] [CrossRef]
- Ajit, N.S.; Verma, R.; Shanmugam, V. Extracellular chitinases of fluorescent pseudomonads antifungal to Fusarium oxysporum f. sp. dianthi causing carnation wilt. Curr. Microbiol. 2006, 52, 310–316. [Google Scholar] [CrossRef] [PubMed]
- Rais, A.; Shakeel, M.; Hafeez, F.Y.; Hassan, M.N. Plant growth promoting rhizobacteria suppress blast disease caused by Pyricularia oryzae and increase grain yield of rice. BioControl 2016, 61, 769–780. [Google Scholar] [CrossRef]
- Van Wees, S.C.; de Swart, E.A.; van Pelt, J.A.; van Loon, L.C.; Pieterse, C.M. Enhancement of induced disease resistance by simultaneous activation of salicylate- and jasmonate-dependent defense pathways in Arabidopsis thaliana. Proc. Natl. Acad. Sci. USA 2000, 97, 8711–8716. [Google Scholar] [CrossRef] [PubMed]
- Ali, S.; Mir, Z.A.; Bhat, J.A.; Chandrashekar, N.; Papolu, P.K.; Rawat, S.; Grover, A. Identification and comparative analysis of Brassica juncea pathogenesis-related genes in response to hormonal, biotic and abiotic stresses. Acta Physiol. Plant 2017, 39, 268. [Google Scholar] [CrossRef]
- Tierens, K.F.; Thomma, B.P.; Brouwer, M.; Schmidt, J.; Kistner, K.; Porzel, A.; Mauch-Mani, B.; Cammue, B.P.; Broekaert, W.F. Study of the role of antimicrobial glucosinolate-derived isothiocyanates in resistance of Arabidopsis to microbial pathogens. Plant Physiol. 2001, 125, 1688–1699. [Google Scholar] [CrossRef] [PubMed]
- Suresh, G.; Gopalakrishnan, G.; Wesley, S.D.; Singh, N.D.P.; Malathi, R.; Rajan, S.S. Insect antifeedant activity of tetranortriterpenoids from the Rutales. A perusal of structural relations. J. Agric. Food Chem. 2001, 50, 4484–4490. [Google Scholar] [CrossRef]
- Guo, Y.; Qiao, D.; Yang, C.; Chen, J.; Li, Y.; Liang, S.; Lin, K.; Chen, Z. Jasmonic acid and glucose synergistically modulate the accumulation of glucosinolates in Arabidopsis thaliana. J. Exp. Bot. 2013, 64, 5707–5719. [Google Scholar] [CrossRef]
- Rogowska, A.; Stpiczyńska, M.; Pączkowski, C.; Szakiel, A. The Influence of Exogenous Jasmonic Acid on the Biosynthesis of Steroids and Triterpenoids in Calendula officinalis Plants and Hairy Root Culture. Int. J. Mol. Sci. 2022, 23, 12173. [Google Scholar] [CrossRef]
- Sanchez, L.; Courteaux, B.; Hubert, J.; Kauffmann, S.; Renault, J.-H.; Clément, C.; Baillieul, F.; Dorey, S. Rhamnolipids elicit defense responses and induce disease resistance against biotrophic, hemibiotrophic, and necrotrophic pathogens that require different signaling pathways in Arabidopsis and highlight a central role for salicylic acid. Plant Physiol. 2012, 160, 1630–1641. [Google Scholar] [CrossRef]
- Maulidah, N.I.; Tseng, T.-S.; Chen, G.-H.; Hsieh, H.-Y.; Chang, S.-F.; Chuang, H.-W. Transcriptome analysis revealed cellular pathways associated with abiotic stress tolerance and disease resistance induced by Pseudomonas aeruginosa in banana plants. Plant Gene 2021, 27, 100321. [Google Scholar] [CrossRef]
- Nouman, W.; Basra, S.M.A.; Yasmeen, A.; Gull, T.; Hussain, S.B.; Zubair, M.; Gul, R. Seed priming improves the emergence potential, growth and antioxidant system of Moringa oleifera under saline conditions. Plant Growth Regul. 2014, 73, 267–278. [Google Scholar] [CrossRef]
- Hasanuzzaman, M.; Bhuyan, M.H.M.B.; Anee, T.I.; Parvin, K.; Nahar, K.; Mahmud, J.A.; Fujita, M. Regulation of ascorbate-glutathione pathway in mitigating oxidative damage in plants under abiotic stress. Antioxidants 2019, 8, 384. [Google Scholar] [CrossRef] [PubMed]
- Brunetti, C.; Guidi, L.; Sebastiani, F.; Tattini, M. Isoprenoids and phenylpropanoids are key components of the antioxidant defense system of plants facing severe excess light stress. Environ. Exp. Bot. 2015, 119, 54–62. [Google Scholar] [CrossRef]
- Celeste Varela, M.; Arslan, I.; Reginato, M.A.; Cenzano, A.M.; Virginia Luna, M. Phenolic compounds as indicators of drought resistance in shrubs from Patagonian shrublands (Argentina). Plant Physiol. Biochem. 2016, 104, 81–91. [Google Scholar] [CrossRef]
- Shomali, A.; Das, S.; Arif, N.; Sarraf, M.; Zahra, N.; Yadav, V.; Aliniaeifard, S.; Chauhan, D.K.; Hasanuzzaman, M. Diverse Physiological Roles of Flavonoids in Plant Environmental Stress Responses and Tolerance. Plants 2022, 18, 3158. [Google Scholar] [CrossRef]
- Sangwan, S.; Shameem, N.; Yashveer, S.; Tanwar, H.; Parray, J.A.; Jatav, H.S.; Sharma, S.; Punia, H.; Sayyed, R.Z.; Almalki, W.H.; et al. Role of Salicylic Acid in Combating Heat Stress in Plants: Insights into Modulation of Vital Processes. Front. Biosci. 2022, 27, 310. [Google Scholar] [CrossRef]
- Su, Y.; Huang, Y.; Dong, X.; Wang, R.; Tang, M.; Cai, J.; Chen, J.; Zhang, X.; Nie, G. Exogenous Methyl Jasmonate Improves Heat Tolerance of Perennial Ryegrass through Alteration of Osmotic Adjustment, Antioxidant Defense, and Expression of Jasmonic Acid-Responsive Genes. Front. Plant Sci. 2021, 12, 664519. [Google Scholar] [CrossRef]
- Fujita, Y.; Fujita, M.; Shinozaki, K.; Yamaguchi-Shinozaki, K. ABA-mediated transcriptional regulation in response to osmotic stress in plants. J. Plant Res. 2011, 124, 509–525. [Google Scholar] [CrossRef]
- Jiang, C.H.; Fan, Z.H.; Xie, P.; Guo, J.H. Bacillus cereus AR156 Extracellular Polysaccharides Served as a Novel Micro-associated Molecular Pattern to Induced Systemic Immunity to Pst DC3000 in Arabidopsis. Front. Microbiol. 2016, 7, 664. [Google Scholar] [CrossRef]
- El-Esawi, M.A.; Alaraidh, I.A.; Alsahli, A.A.; Alamri, S.A.; Ali, H.M.; Alayafi, A.A. Bacillus firmus (SW5) augments salt tolerance in soybean (Glycine max L.) by modulating root system architecture, antioxidant defense systems and stress-responsive genes expression. Plant Physiol. Biochem. 2018, 132, 375–384. [Google Scholar] [CrossRef]
- Sukkasem, P.; Kurniawan, A.; Kao, T.C.; Chuang, H.W. A multifaceted rhizobacterium Bacillus licheniformis functions as a fungal antagonist and a promoter of plant growth and abiotic stress tolerance. Environ. Exp. Bot. 2018, 155, 541–551. [Google Scholar] [CrossRef]
- Kurniawan, A.; Chuang, H.W. Rhizobacterial Bacillus mycoides functions in stimulating the antioxidant defence system and multiple phytohormone signalling pathways to regulate plant growth and stress tolerance. J. Appl. Microbiol. 2022, 132, 1260–1274. [Google Scholar] [CrossRef]
- Griffiths, R.I.; Whiteley, A.S.; O’Donnell, A.G.; Bailey, M.J. Rapid Method for Coextraction of DNA and RNA from Natural Environments for Analysis of Ribosomal DNA- and rRNA-Based Microbial Community Composition. Appl. Environ. Microbiol. 2000, 66, 5488–5491. [Google Scholar] [CrossRef] [PubMed]
- Weisburg, W.G.; Barns, S.M.; Pelletier, D.A.; Lane, D.J. 16S ribosomal DNA amplification for phylogenetic study. J. Bacteriol. 1991, 173, 697–703. [Google Scholar] [CrossRef]
- Altschul, S.F.; Gish, W.; Miller, W.; Myers, E.W.; Lipman, D.J. Basic local alignment search tool. J. Mol. Biol. 1990, 215, 403–410. [Google Scholar] [CrossRef] [PubMed]
- Larkin, M.A.; Blackshields, G.; Brown, N.P.; Chenna, R.; McGettigan, P.A.; McWilliam, H.; Valentin, F.; Wallace, I.M.; Wilm, A.; Lopez, R.; et al. Clustal W and clustal X version 2.0. Bioinformatics 2007, 23, 2947–2948. [Google Scholar] [CrossRef]
- Kumar, S.; Stecher, G.; Li, M.; Knyaz, C.; Tamura, K. MEGA X: Molecular evolutionary genetics analysis across computing platforms. Mol. Biol. Evol. 2018, 35, 1547–1549. [Google Scholar] [CrossRef]
- De Coster, W.; D’Hert, S.; Schultz, D.T.; Cruts, M.; Van Broeckhoven, C. NanoPack: Visualizing and processing long-read sequencing data. Bioinformatics 2018, 34, 2666–2669. [Google Scholar] [CrossRef]
- Bankevich, A.; Nurk, S.; Antipov, D.; Gurevich, A.A.; Dvorkin, M.; Kulikov, A.S.; Lesin, V.M.; Nikolenko, S.I.; Pham, S.; Prjibelski, A.D.; et al. SPAdes: A New Genome Assembly Algorithm and Its Applications to Single-Cell Sequencing. J. Comput. Biol. 2012, 19, 455–477. [Google Scholar] [CrossRef]
- Majoros, W.H.; Pertea, M.; Salzberg, S.L. TigrScan and GlimmerHMM: Two open-source ab initio eukaryotic gene-finders. Bioinformatics 2004, 20, 2878–2879. [Google Scholar] [CrossRef]
- Lagesen, K.; Hallin, P.; Rødland, E.A.; Staerfeldt, H.H.; Rognes, T.; Ussery, D.W. RNAmmer: Consistent and rapid annotation of ribosomal RNA genes. Nucleic Acids Res. 2007, 35, 3100–3108. [Google Scholar] [CrossRef] [PubMed]
- Lowe, T.M.; Eddy, S.R. tRNAscan-SE: A program for improved detection of transfer RNA genes in genomic sequence. Nucleic Acids Res. 1997, 25, 955–964. [Google Scholar] [CrossRef] [PubMed]
- Chen, T.W.; Gan, R.C.R.; Wu, T.H.; Huang, P.J.; Lee, C.Y.; Chen, Y.Y.M.; Chen, C.C.; Tang, P. FastAnnotator- an efficient transcript annotation web tool. BMC Genom. 2012, 13, 7313. [Google Scholar] [CrossRef]
- Simonetti, E.; Hernández, A.I.; Kerber, N.L.; Pucheu, N.L.; Carmona, M.A.; García, A.F. Protection of canola (Brassica napus) against fungal pathogens by strains of biocontrol rhizobacteria. Biocontrol. Sci. Technol. 2012, 22, 111–115. [Google Scholar] [CrossRef]
- Aydi Ben Abdallah, R.; Jabnoun-Khiareddine, H.; Mejdoub-Trabelsi, B.; Daami-Remadi, M. Soil-borne and compost-borne Aspergillus species for biologically controlling post-harvest diseases of potatoes incited by fusarium sambucinum and Phytophthora erythroseptica. Plant Pathol. Microbiol. 2015, 6, 10. [Google Scholar] [CrossRef]
- Patten, C.L.; Glick, B.R. Role of Pseudomonas putida indoleacetic acid in development of the host plant root system. Appl. Environ. Microbiol. 2002, 68, 3795–3801. [Google Scholar] [CrossRef]
- Nautiyal, C.S.; Bhadauria, S.; Kumar, P.; Lal, H.; Mondal, R.; Verma, D. Stress induced phosphate solubilization in bacteria isolated from alkaline soils. FEMS Microbiol. Lett. 2000, 182, 291–296. [Google Scholar] [CrossRef]
- Bruce, R.J.; West, C.A. Elicitation of lignin biosynthesis and isoperoxidase activity by pectic fragments in suspension cultures of castor bean. Plant Physiol. 1989, 9, 889–897. [Google Scholar] [CrossRef]
- Mawlong, I.; Sujith Kumar, M.S.; Gurung, B.; Singh, K.H.; Singh, D. A simple spectrophotometric method for estimating total glucosinolates in mustard de-oiled cake. Int. J. Food Prop. 2017, 20, 3274–3281. [Google Scholar] [CrossRef]
- Chang, C.L.; Lin, C.S.; Lai, G.H. Phytochemical characteristics, free radical scavenging activities, and neuroprotection of five medicinal plant extracts. Evid. Based Complement Altern. Med. 2011, 2012, 984295. [Google Scholar] [CrossRef]
- Quettier-Deleu, C.; Gressier, B.; Vasseur, J.; Dine, T.; Brunet, C.; Luyckx, M.; Cazin, M.; Cazin, J.; Bailleul, F.; Trotin, F. Phenolic compounds and antioxidant activities of buckwheat (Fagopyrum esculentum Moench) hulls and flour. J. Ethnopharmacol. 2000, 72, 35–42. [Google Scholar] [CrossRef]
- Li, H.B.; Cheng, K.W.; Wong, C.C.; Fan, K.W.; Chen, F.; Jiang, Y. Evaluation of antioxidant capacity and total phenolic content of different fractions of selected microalgae. Food Chem. 2007, 102, 771–776. [Google Scholar] [CrossRef]
- Aebi, H.; Lester, P. Catalase in vitro. Meth. Enzymol. 1984, 105, 121–126. [Google Scholar] [CrossRef]
- DeLong, J.M.; Prange, R.K.; Hodges, D.M.; Forney, C.F.; Bishop, M.C.; Quilliam, M. Using a modified ferrous oxidation-xylenol orange (FOX) assay for detection of lipid hydroperoxides in plant tissue. J. Agric. Food Chem. 2002, 50, 248–254. [Google Scholar] [CrossRef] [PubMed]
- Parcy, F.; Valon, C.; Raynal, M.; Gaubier-Comella, P.; Delseny, M.; Giraudat, J. Regulation of gene expression programs during Arabidopsis seed development: Roles of the ABI3 locus and of endogenous abscisic acid. Plant Cell 1994, 6, 1567–1582. [Google Scholar] [CrossRef] [PubMed]
- Dertz, E.A.; Xu, J.; Stintzi, A.; Raymond, K.N. Bacillibactin-mediated iron transport in Bacillus subtilis. J. Am. Chem. Soc. 2006, 128, 22–23. [Google Scholar] [CrossRef]
- Patel, C.N.; Wortham, B.W.; Lines, J.L.; Fetherston, J.D.; Perry, R.D.; Oliveira, M.A. Polyamines are essential for the formation of plague biofilm. J. Bacteriol. 2006, 188, 2355–2363. [Google Scholar] [CrossRef]
- Park, A.R.; Kim, J.; Kim, B.; Ha, A.; Son, J.Y.; Song, C.W.; Song, H.; Kim, J.C. Exogenous Bio-Based 2,3-Butanediols Enhanced Abiotic Stress Tolerance of Tomato and Turfgrass under Drought or Chilling Stress. J. Microbiol. Biotechnol. 2022, 32, 582–593. [Google Scholar] [CrossRef]
- Singh, P.; Chauhan, P.K.; Upadhyay, S.K.; Singh, R.K.; Dwivedi, P.; Wang, J.; Jain, D.; Jiang, M. Mechanistic Insights and Potential Use of Siderophores Producing Microbes in Rhizosphere for Mitigation of Stress in Plants Grown in Degraded Land. Front. Microbiol. 2022, 13, 898979. [Google Scholar] [CrossRef]
- Geng, C.; Nie, X.; Tang, Z.; Zhang, Y.; Lin, J.; Sun, M.; Peng, D. A novel serine protease, Sep1, from Bacillus firmus DS-1 has nematicidal activity and degrades multiple intestinal-associated nematode proteins. Sci. Rep. 2016, 6, 25012. [Google Scholar] [CrossRef]
- Jack, R.W.; Tagg, J.R.; Ray, B. Bacteriocins of gram-positive bacteria. Microbiol. Rev. 1995, 59, 171–200. [Google Scholar] [CrossRef] [PubMed]
- Veliz, E.A.; Martínez-Hidalgo, P.; Hirsch, A.M. Chitinase-producing bacteria and their role in biocontrol. AIMS Microbiol. 2017, 3, 689–705. [Google Scholar] [CrossRef] [PubMed]
- Margalef, O.; Sardans, J.; Fernández-Martínez, M.; Molowny-Horas, R.; Janssens, I.A.; Ciais, P.; Goll, D.; Richter, A.; Obersteiner, M.; Asensio, D.; et al. Global patterns of phosphatase activity in natural soils. Sci. Rep. 2017, 7, 1337. [Google Scholar] [CrossRef]
- Schaller, G.E.; Bishopp, A.; Kieber, J.J. The Yin-Yang of Hormones: Cytokinin and Auxin Interactions in Plant Development. Plant Cell 2015, 27, 44–63. [Google Scholar] [CrossRef]
- Li, L.; Sun, Y.; Chen, F.; Hao, D.; Tan, J. An alkaline protease from Bacillus cereus NJSZ-13 can act as a pathogenicity factor in infection of pinewood nematode. BMC Microbiol. 2023, 23, 10. [Google Scholar] [CrossRef] [PubMed]
- Spaepen, S.; Vanderleyden, J.; Remans, R. Indole-3-acetic acid in microbial and microorganism-plant signaling. FEMS Microbiol. Rev. 2007, 31, 425–448. [Google Scholar] [CrossRef] [PubMed]
- Yousef, N.M.H. Capability of plant growth-promoting rhizobacteria (PGPR) for producing indole acetic acid (IAA) under extreme conditions. Eur. J. Biol. Res. 2018, 8, 174–182. [Google Scholar] [CrossRef]
- Hussain, A.; Ullah, I.; Naseem, M. Plant-Associated Microbes Alter Root Growth by Modulating Root Apical Meristem. Methods Mol. Biol. 2020, 2094, 49–58. [Google Scholar] [CrossRef]
- Lavenus, J.; Goh, T.; Roberts, I.; Guyomarc’h, S.; Lucas, M.; De Smet, I.; Fukaki, H.; Beeckman, T.; Bennett, M.; Laplaze, L. Lateral root development in Arabidopsis: Fifty shades of auxin. Trends Plant Sci. 2013, 18, 450–458. [Google Scholar] [CrossRef]
- Weijers, D.; Wagner, D. Transcriptional responses to the auxin hormone. Annu. Rev. Plant Biol. 2016, 67, 539–574. [Google Scholar] [CrossRef]
- Tyagi, S.; Kim, K.; Cho, M.; Lee, K.-J. Volatile dimethyl disulfide affects root system architecture of Arabidopsis via modulation of canonical auxin signaling pathways. Environ. Sustain. 2019, 2, 211–216. [Google Scholar] [CrossRef]
- Meldau, D.G.; Meldau, S.; Hoang, L.H.; Underberg, S.; Wünsche, H.; Baldwina, I.T. Dimethyl Disulfide Produced by the Naturally Associated Bacterium Bacillus sp B55 Promotes Nicotiana attenuata Growth by Enhancing Sulfur Nutrition. Plant Cell 2013, 25, 2731–2747. [Google Scholar] [CrossRef] [PubMed]
- Chamam, A.; Sanguin, H.; Bellvert, F.; Meiffren, G.; Comte, G.; Wisniewski-Dyé, F.; Bertrand, C.; Prigent-Combaret, C. SG2-type R2R3-MYB transcription factor MYB15 controls defense-induced lignification and basal immunity in Arabidopsis. Plant Cell 2017, 29, 1907–1926. [Google Scholar] [CrossRef]
- Cheng, Z.; Li, J.-F.; Niu, Y.; Zhang, X.-C.; Woody, O.Z.; Xiong, Y.; Djonović, S.; Millet, Y.; Bush, J.; McConkey, B.J. Pathogen-Secreted Proteases Activate a Novel Plant Immune Pathway. Nature 2015, 521, 213–216. [Google Scholar] [CrossRef] [PubMed]
- Rais, A.; Jabeen, Z.; Shair, F.; Hafeez, F.Y.; Hassan, M.N. Bacillus spp., a bio-control agent enhances the activity of antioxidant defense enzymes in rice against Pyricularia oryzae. PLoS ONE 2017, 12, e0187412. [Google Scholar] [CrossRef]
- Parankusam, S.; Bhatnagar-Mathur, P.; Sharma, K.K. Heat responsive proteome changes reveal molecular mechanisms underlying heat tolerance in chickpea. Environ. Exp. Bot. 2017, 141, 132–144. [Google Scholar] [CrossRef]
- Jayaraman, K.; Sevanthi, A.M.; Sivakumar, S.R.; Viswanathan, C.; Mohapatra, T.; Mandal, P.K. Stress-inducible expression of chalcone isomerase2 gene improves accumulation of flavonoids and imparts enhanced abiotic stress tolerance to rice. Environ. Exp. Bot. 2021, 190, 104582. [Google Scholar] [CrossRef]
- Hara, M.; Harazaki, A.; Tabata, K. Administration of isothiocyanates enhances heat tolerance in Arabidopsis thaliana. Plant Growth Regul. 2013, 69, 71–77. [Google Scholar] [CrossRef]
- Ludwig-Muller, J.; Krishna, P.; Forreiter, C. A glucosinolate mutant of Arabidopsis is thermosensitive and defective in cytosolic Hsp90 expression after heat stress. Plant Physiol. 2000, 123, 949–958. [Google Scholar] [CrossRef]
- Zou, L.; Yang, F.; Ma, Y.; Wu, Q.; Yi, K.; Zhang, D. Isoprene acts as a signaling molecule in gene networks important for stress responses and plant growth. Plant Physiol. 2019, 180, 124–152. [Google Scholar] [CrossRef]
- Chuang, H.-W.; Tseng, T.-S.; Hsieh, H.-Y.; Kao, T.-C.; Chen, G.-H. Common Cellular Events Implicated in the Regulation of Cold Stress Tolerance and Soft Rot Resistance Induced by Metabolites of Pseudomonas Aeruginosa in Phalaenopsis Orchids. ACBR 2022, 1, 5–21. [Google Scholar] [CrossRef]
- Zhang, S.-H.; Yang, Q.; Ma, R.-C. Erwinia carotovora ssp. carotovora infection induced “defense lignin” accumulation and lignin biosynthetic gene expression in Chinese cabbage (Brassica rapa L. ssp. pekinensis). J. Integr. Plant Biol. 2007, 49, 993–1002. [Google Scholar] [CrossRef]
- Ge, Y.; Wang, Y.; Han, J.; Lu, Y.; Yue, X.; Zhang, X.; Wang, Y.; Shen, S.; Zhao, J.; Ma, W.; et al. Transcriptome analysis reveals resistance induced by Benzothiadiazole against soft rot in Chinese cabbage. Sci. Hortic. 2023, 315, 111978. [Google Scholar] [CrossRef]
- Brader, G.; Mikkelsen, M.D.; Halkier, B.A.; Palva, E.T. Altering glucosinolate profiles modulates disease resistance in plants. Plant J. 2006, 46, 758–767. [Google Scholar] [CrossRef] [PubMed]
- Yi, S.Y.; Lee, M.; Park, S.K.; Lu, L.; Lee, G.; Kim, S.G.; Kang, S.Y.; Lim, Y.P. Jasmonate regulates plant resistance to Pectobacterium brasiliense by inducing indole glucosinolate biosynthesis. Front. Plant Sci. 2022, 13, 964092. [Google Scholar] [CrossRef]
- Gerayeli, N.; Baghaee-Ravari, S.; Tarighi, S. Evaluation of the antagonistic potential of Bacillus strains against Pectobacterium carotovorum subsp. carotovorum and their role in the induction of resistance to potato soft rot infection. Eur. J. Plant Pathol. 2018, 150, 1049–1063. [Google Scholar] [CrossRef]
- Ngadze, E.; Icishahayo, D.; Coutinho, T.A.; Van der Waals, J.E. Role of polyphenol oxidase, peroxidase, phenylalanine ammonia lyase, chlorogenic acid, and total soluble phenols in resistance of potatoes to soft rot. Plant Dis. 2012, 96, 186–192. [Google Scholar] [CrossRef]
- Daniel, B.; Pavkov-Keller, T.; Steiner, B.; Dordic, A.; Gutmann, A.; Nidetzky, B.; Sensen, C.W.; van der Graaff, E.; Wallner, S.; Gruber, K.; et al. Oxidation of Monolignols by Members of the Berberine Bridge Enzyme Family Suggests a Role in Plant Cell Wall Metabolism. J. Biol. Chem. 2015, 290, 18770–18781. [Google Scholar] [CrossRef]
- Zhong, R.; Morrison, W.H.; Negrel, J.; Ye, Z.-H. Dual methylation pathways in lignin biosynthesis. Plant Cell 1998, 10, 2033–2045. [Google Scholar] [CrossRef]
- Fazio, G.C.; Xu, R.; Matsuda, S.P.T. Genome mining to identify new plant triterpenoids. J. Am. Chem. Soc. 2004, 126, 5678–5679. [Google Scholar] [CrossRef]
- Poyraz, I. Partial Cloning and DNA Sequencing of Terpene Synthase-4 Gene (TPS-4) in Origanumonites L. Eur. J. Lipid Sci. Technol. 2017, 6, 51. [Google Scholar]
- Xiang, T.; Shibuya, M.; Katsube, Y.; Tsutsumi, T.; Otsuka, M.; Zhang, H.; Masuda, K.; Ebizuka, Y. A New Triterpene Synthase from Arabidopsis t haliana Produces a Tricyclic Triterpene with Two Hydroxyl Groups. Org. Lett. 2006, 8, 2835–2838. [Google Scholar] [CrossRef] [PubMed]
- Nafisi, M.; Goregaoker, S.; Botanga, C.J.; Glawischnig, E.; Olsen, C.E.; Halkier, B.A.; Glazebrook, J. Arabidopsis cytochrome P450 monooxygenase 71A13 catalyzes the conversion of indole-3-acetaldoxime in camalexin synthesis. Plant Cell 2007, 19, 2039–2052. [Google Scholar] [CrossRef]
- Reinhardt, N.; Fischer, J.; Coppi, R.; Blum, E.; Brandt, W.; Dräger, B. Substrate flexibility and reaction specificity of tropinone reductase-like shortchain dehydrogenases. Bioorg. Chem. 2014, 53, 37–49. [Google Scholar] [CrossRef] [PubMed]
- Pfalz, M.; Mikkelsen, M.D.; Bednarek, P.; Olsen, C.E.; Halkier, B.A.; Kroymann, J. Metabolic Engineering in Nicotiana benthamiana Reveals Key Enzyme Functions in Arabidopsis Indole Glucosinolate Modification. Plant Cell 2011, 23, 716–729. [Google Scholar] [CrossRef] [PubMed]
- Rajniak, J.; Barco, B.; Clay, N.K.; Sattely, E.S. A new cyanogenic metabolite in Arabidopsis required for inducible pathogen defence. Nature 2015, 525, 376–379. [Google Scholar] [CrossRef] [PubMed]
- Vogel, G.; Fiehn, O.; Jean-Richard-dit-Bressel, L.; Boller, T.; Wiemken, A.; Aeschbacher, R.A.; Wingler, A. Trehalose metabolism in Arabidopsis: Occurrence of trehalose and molecular cloning and characterization of trehalose-6-phosphate synthase homologues. J. Exp. Bot. 2001, 52, 1817–1826. [Google Scholar] [CrossRef]
- Mattioli, R.; Falasca, G.; Sabatini, S.; Altamura, M.M.; Costantino, P.; Trovato, M. The proline biosynthetic genes P5CS1 and P5CS2 play overlapping roles in Arabidopsis flower transition but not in embryo development. Physiol. Plant. 2009, 137, 72–85. [Google Scholar] [CrossRef]
- Kwon, S.J.; Jin, H.C.; Lee, S.; Nam, M.H.; Chung, J.H.; Kwon, S.I.; Ryu, C.M.; Park, O.K. GDSL lipase-like 1 regulates systemic resistance associated with ethylene signaling in Arabidopsis. Plant J. 2009, 58, 235–245. [Google Scholar] [CrossRef]
- Louis, J.; Lorenc-Kukula, K.; Singh, V.; Reese, J.; Jander, G.; Shah, J. Antibiosis against the green peach aphid requires the Arabidopsis thaliana MYZUS PERSICAE-INDUCED LIPASE1 gene. Plant J. 2010, 64, 800–811. [Google Scholar] [CrossRef]
- Bruce, T.J.A.; Matthes, M.C.; Chamberlain, K.; Woodcock, C.M.; Mohib, A.; Webster, B.; Smart, L.E.; Birkett, M.A.; Pickett, J.A.; Napier, J.A. cis-Jasmone induces Arabidopsis genes that affect the chemical ecology of multitrophic interactions with aphids and their parasitoids. Proc. Natl. Acad. Sci. USA 2008, 105, 4553–4558. [Google Scholar] [CrossRef] [PubMed]
- Adio, A.M.; Casteel, C.L.; De Vos, M.; Kim, J.H.; Joshi, V.; Li, B.; Juéry, C.; Daron, J.; Kliebenstein, D.J.; Jander, G. Biosynthesis and defensive function of Nδ-acetylornithine, a jasmonate-induced Arabidopsis metabolite. Plant Cell 2011, 23, 3303–3318. [Google Scholar] [CrossRef] [PubMed]
- Clemente, M.; Corigliano, M.G.; Pariani, S.A.; Sánchez-López, E.F.; Sander, V.A.; Ramos-Duarte, V.A. Plant Serine Protease Inhibitors: Biotechnology Application in Agriculture and Molecular Farming. Int. J. Mol. Sci. 2019, 20, 1345. [Google Scholar] [CrossRef]
- Kumar, M.; Yusuf, M.A.; Yadav, P.; Narayan, S.; Kumar, M. Overexpression of Chickpea Defensin Gene Confers Tolerance to Water-Deficit Stress in Arabidopsis thaliana. Front. Plant Sci. 2019, 10, 290. [Google Scholar] [CrossRef]
- Shahzad, Z.; Ranwez, V.; Fizames, C.; Marquès, L.; Le Martret, B.; Alassimone, J.; Godé, C.; Lacombe, E.; Castillo, T.; Saumitou-Laprade, P.; et al. Plant Defensin type 1 (PDF1): Protein promiscuity and expression variation within the Arabidopsis genus shed light on zinc tolerance acquisition in Arabidopsis halleri. New Phytol. 2013, 200, 820–833. [Google Scholar] [CrossRef] [PubMed]
- Wu, Y.; Zhou, J.; Li, C.; Ma, Y. Antifungal and plant growth promotion activity of volatile organic compounds produced by Bacillus amyloliquefaciens. Microbiologyopen 2019, 8, e00813. [Google Scholar] [CrossRef] [PubMed]
- Liu, S.; Tian, Y.; Jia, M.; Lu, X.; Yue, L.; Zhao, X.; Jin, W.; Wang, Y.; Zhang, Y.; Xie, Z.; et al. Induction of Salt Tolerance in Arabidopsis thaliana by Volatiles From Bacillus amyloliquefaciens FZB42 via the Jasmonic Acid Signaling Pathway. Front. Microbiol. 2020, 11, 562934. [Google Scholar] [CrossRef]
- Li, Y.; Zhang, Y.; Wang, Q.-X.; Wang, T.-T.; Cao, X.-L.; Zhao, Z.-X.; Zhao, S.-L.; Xu, Y.-J.; Xiao, Z.-Y.; Li, J.-L. RESISTANCE TO POWDERY MILDEW8.1 boosts pattern-triggered immunity against multiple pathogens in Arabidopsis and rice. Plant Biotechnol. J. 2018, 16, 428–441. [Google Scholar] [CrossRef]
- Salzman, R.A.; Koiwa, H.; Ibeas, J.I.; Pardo, J.M.; Hasegawa, P.M.; Bressan, R.A. Inorganic cations mediate plant PR5 protein antifungal activity through fungal Mnn1-and Mnn4-regulated cell surface glycans. Mol. Plant Microbe Interact. 2004, 17, 780–788. [Google Scholar] [CrossRef]
- Taveira, G.B.; Mello, É.O.; Carvalho, A.O.; Regente, M.; Pinedo, M.; de La Canal, L.; Rodrigues, R.; Gomes, V.M. Antimicrobial activity and mechanism of action of a thionin-like peptide from Capsicum annuum fruits and combinatorial treatment with fluconazole against Fusarium solani. Pept. Sci. 2017, 108, e23008. [Google Scholar] [CrossRef]
- Park, E.-J.; Kim, T.-H. Arabidopsis OSMOTIN 34 functions in the ABA signaling pathway and is regulated by proteolysis. Int. J. Mol. Sci. 2021, 22, 7915. [Google Scholar] [CrossRef] [PubMed]
- Labrou, N.E.; Papageorgiou, A.C.; Pavli, O.; Flemetakis, E. Plant GSTome: Structure and functional role in xenome network and plant stress response. Curr. Opin. Biotechnol. 2015, 32, 186–194. [Google Scholar] [CrossRef] [PubMed]
- Csiszár, J.; Gallé, A.; Horváth, E.; Dancsó, P.; Gombos, M.; Váry, Z.; Erdei, L.; Györgyey, J.; Tari, I. Different peroxidase activities and expression of abiotic stress-related peroxidases in apical root segments of wheat genotypes with different drought stress tolerance under osmotic stress. Plant Physiol. Biochem. 2012, 52, 119–129. [Google Scholar] [CrossRef] [PubMed]
- Hasanuzzaman, M.; Nahar, K.; Hossain, M.S.; Mahmud, J.A.; Rahman, A.; Inafuku, M.; Oku, H.; Fujita, M. Coordinated actions of glyoxalase and antioxidant defense systems in conferring abiotic stress tolerance in plants. Int. J. Mol. Sci. 2017, 18, 200. [Google Scholar] [CrossRef] [PubMed]
- Shigeto, J.; Itoh, Y.; Hirao, S.; Ohira, K.; Fujita, K.; Tsutsumi, Y. Simultaneously disrupting AtPrx2, AtPrx25 and AtPrx71 alters lignin content and structure in Arabidopsis stem. J. Integr. Plant Biol. 2015, 57, 349–356. [Google Scholar] [CrossRef] [PubMed]
- Vogelsang, L.; Dietz, K.J. Plant thiol peroxidases as redox sensors and signal transducers in abiotic stress acclimation. Free Radic. Biol. Med. 2022, 193, 764–778. [Google Scholar] [CrossRef]
- Waadt, R.; Seller, C.A.; Hsu, P.K.; Takahashi, Y.; Munemasa, S.; Julian, I. Plant hormone regulation of abiotic stress responses. Front. Plant Sci. 2022, 23, 680–694. [Google Scholar] [CrossRef]
- Pollmann, S.; Düchting, P.; Weiler, E.W. Tryptophan-dependent indole-3-acetic acid biosynthesis by ‘IAA-synthase’proceeds via indole-3-acetamide. Phytochemistry 2009, 70, 523–531. [Google Scholar] [CrossRef]
- Zhang, H.; Kim, M.S.; Krishnamachari, V.; Payton, P.; Sun, Y.; Grimson, M.; Farag, M.A.; Ryu, C.M.; Allen, R.; Melo, I.S.; et al. Rhizobacterial volatile emissions regulate auxin homeostasis and cell expansion in Arabidopsis. Planta 2007, 226, 839–851. [Google Scholar] [CrossRef]
- Nambara, E.; Marion-Poll, A. ABA action and interactions in seeds. Trends Plant Sci. 2015, 20, 42–51. [Google Scholar] [CrossRef] [PubMed]
- Creelman, R.A.; Mullet, J.E. Jasmonic acid distribution and action in plants: Regulation during development and response to biotic and abiotic stress. Proc. Natl. Acad. Sci. USA 1995, 92, 4114–4119. [Google Scholar] [CrossRef] [PubMed]
- Tieman, D.; Zeigler, M.; Schmelz, E.; Taylor, M.; Rushing, S.; Jones, J.B.; Klee, H.J. Functional analysis of a tomato salicylic acid methyl transferase and its role in synthesis of the flavor volatile methyl salicylate. Plant J. 2010, 62, 113–123. [Google Scholar] [CrossRef] [PubMed]
- Sharifi, R.; Ryu, C.M. Are bacterial volatile compounds poisonous odors to a fungal pathogen Botrytis cinerea, alarm signals to Arabidopsis seedlings for eliciting induced resistance, or both? Front. Microbiol. 2016, 7, 196. [Google Scholar] [CrossRef] [PubMed]
- Rizza, A.; Tang, B.; Stanley, C.E.; Grossmann, G.; Owen, M.R.; Band, L.R.; Jones, A.M. Differential biosynthesis and cellular permeability explain longitudinal gibberellin gradients in growing roots. Proc. Natl. Acad. Sci. USA 2021, 118, e1921960118. [Google Scholar] [CrossRef]
- Verma, V.; Ravindran, P.; Kumar, P.P. Plant hormone-mediated regulation of stress responses. BMC Plant Biol. 2016, 16, 86. [Google Scholar] [CrossRef]
- Bodenhausen, N.; Reymond, P. Signaling pathways controlling induced resistance to insect herbivores in Arabidopsis. Mol. Plant Microbe. Interact. 2007, 20, 1406–1420. [Google Scholar] [CrossRef] [PubMed]
- Scarpeci, T.E.; Zanor, M.; Mueller-Roeber, B.; Valle, E.M. Overexpression of AtWRKY30 enhances abiotic stress tolerance during early growth stages in Arabidopsis thaliana. Plant Mol. Biol. 2013, 83, 265–277. [Google Scholar] [CrossRef]
- Yu, Y.; Wang, L.; Chen, J.; Liu, Z.; Park, C.M.; Xiang, F. WRKY71 Acts Antagonistically Against Salt-Delayed Flowering in Arabidopsis thaliana. Plant Cell Physiol. 2018, 59, 414–422. [Google Scholar] [CrossRef]
- Peng, X.; Hu, Y.; Tang, X.; Zhou, P.; Deng, X.; Wang, H.; Guo, Z. Constitutive expression of rice WRKY30 gene increases the endogenous jasmonic acid accumulation, PR gene expression and resistance to fungal pathogens in rice. Planta 2012, 236, 1485–1498. [Google Scholar] [CrossRef]
- Chujo, T.; Kato, T.; Yamada, K.; Takai, R.; Akimoto-Tomiyama, C.; Minami, E.; Nagamura, Y.; Shibuya, N.; Yasuda, M.; Nakashita, H. Characterization of an elicitor-induced rice WRKY gene, OsWRKY71. Biosci. Biotechnol. Biochem. 2008, 72, 240–245. [Google Scholar] [CrossRef]
- Gao, R.; Liu, P.; Yong, Y.; Wong, S.M. Genome-wide transcriptomic analysis reveals correlation between higher WRKY61 expression and reduced symptom severity in Turnip crinkle virus infected Arabidopsis thaliana. Sci. Rep. 2016, 6, 24604. [Google Scholar] [CrossRef] [PubMed]
- Yu, R.; Tang, Y.; Liu, C.; Du, X.; Miao, C.; Shi, G. Comparative transcriptomic analysis reveals the roles of ROS scavenging genes in response to cadmium in two pak choi cultivars. Sci. Rep. 2017, 7, 9217. [Google Scholar] [CrossRef] [PubMed]
- Zhong, R.; Lee, C.; Zhou, J.; McCarthy, R.L.; Ye, Z.H. A battery of transcription factors involved in the regulation of secondary cell wall biosynthesis in Arabidopsis. Plant Cell 2008, 20, 2763–2782. [Google Scholar] [CrossRef] [PubMed]
- Singh, S.; Singh, A.; Kumar, S.; Mittal, P.; Singh, I.K. Protease inhibitors: Recent advancement in its usage as a potential biocontrol agent for insect pest management. Insect Sci. 2020, 27, 186–201. [Google Scholar] [CrossRef] [PubMed]

| Gene | Forward Primer | Reverse Primer |
|---|---|---|
| Actin 2 | 5′CGGTAACATTGTGCTCAGTG3′ | 5′GTGAACGATTCCTGGACCTG3′ |
| IGMT1 | 5′ACAATCGCGGTCGTTAAGAA3′ | 5′GCTCCACACCGGGATAAGAA3′ |
| CYP82C2 | 5′CAGGCTCTTCATTGGCCATGC3′ | 5′CTTCCTTAAGACGTGGACTG3′ |
| TPS4 | 5′GCCACTGATGGCACATGGTG3′ | 5′GTAGAAGCATGGTGCGAATA3′ |
| THAS1 | 5′GAAGCAATTCGTAAAGCAGT3′ | 5′GAGACGTCGCAGAGCATGTG3′ |
| MRN1 | 5′TCTGAAGCTATACGTAGAGC3′ | 5′CGCAGAGCATTTGTGTACAA3′ |
| PDF1.4 | 5′ATGGCTTCTTCTTACACACT3′ | 5′AGCAGAAACATGCGAAACCC3′ |
| TIP1 | 5′ATGGCAAAGGCTATCGTTTC3′ | 5′GTTACTGCCCTGTCCCCAAC3′ |
| THI2 | 5′CTGCCCTTCCAACCAAGCTA3′ | 5′TTGTTCCGACGCTCCATTCA3′ |
| UPI | 5′AAAGCTCATGGCCAGAGCTT3′ | 5′CGATGATAGGAATTTGAACA3′ |
| NIT2 | 5′CGTTTACGACACTCCGATTG3′ | 5′CTGGTCTCGAGTAATGTCCA3′ |
| SDR4 | 5′GCTTCTAAGCACGCGCTTCT3′ | 5′TCATGAGCTTAACGACGCTA3′ |
| LOX1 | 5′CGGACAGTATCCAGTTGCTG3′ | 5′GTTCTTGAGAGTGTCGTCGT3′ |
| WRKY30 | 5′GATAGAACGCTGGACGATGG3′ | 5′CGGTTCGAGGTTTTGTATCG3′ |
| WRKY61 | 5′GTGCAGCTTACGGCAACATT3′ | 5′CAGCCGGTAAAGATGGCACT3′ |
| WRKY71 | 5′CATCCGATCCCATCGACGTT3′ | 5′GAAGGAACAATGTCCTGAAG3 |
| Acc. No. | Gene Description | Position |
|---|---|---|
| Bacteriocin | ||
| EDX55115 | bacteriocin O-metyltransferase | 407364-407603 |
| WP_001071385 | heterocycloanthracin/sonorensin family bacteriocin | 4222458-4222213 |
| WP_041184522 | heterocycloanthracin/sonorensin family bacteriocin | 4290218-4289925 |
| WP_014893786 | bacteriocin-processing peptidase family protein | 4709577-4705375 |
| WP_046648645 | bacteriocin biosynthesis protein SagD | 58276-56987 |
| WP_000067649 | thiazole-containing bacteriocin maturation protein | 364592-366403 |
| Siderophore | ||
| -bacillibactin | ||
| WP_000616755 | isochorismate synthase DhbC | 2193083-2194477 |
| WP_001133933 | non-ribosomal peptide synthetase EntF | 4559229-4552072 |
| WP_001007250 | isochorismatase DhbB | 24560156-4559263 |
| WP_000955359 | (2,3-dihydroxybenzoyl)adenylate synthase EntE | 4561797-4560181 |
| WP_000657800 | isochorismate synthase DhbC | 4563009-4561810 |
| WP_001048422 | 2,3-DHB DhbA | 4563806-4563036 |
| VOCs | ||
| - 2,3-butanediol | ||
| WP_000215033 | alpha-acetolactate decarboxylase | 721764-721006 |
| WP_000813479 | acetolactate synthase large subunit | 5010240-5008525 |
| WP_000822944 | acetolactate synthase small subunit | 247570-247061 |
| WP_000095846 | acetolactate synthase large subunit | 249267-247567 |
| WP_000642458 | 2,3-butanediol dehydrogenase | 3763547-3764614 |
| AAS39887 | acetolactate synthase | 723478-721781 |
| -dimethyl disulfide | ||
| WP_000460299 | methionine gamma-lyase | 3328355-3329626 |
| WP_000726591 | methionine gamma-lyase | 2387529-2388707 |
| WP_001201908 | cystathionine gamma-lyase | 2694257-2695390 |
| WP_000122291 | cystathionine beta-lyase | 2797135-2795972 |
| -terpenoids | ||
| WP_000251030 | IPP isomerase | 153587-152538 |
| EEL15746 | DXP reductoisomerase | 3201707-3202921 |
| WP_000288295 | MEP cytidylyltransferase, ispD | 1488120-1487440 |
| Phytohormones | ||
| -IAA | ||
| WP_000080294 | aldehyde dehydrogenase DhaS | 3490691-3489207 |
| WP_000537830 | tryptophan synthase trpA | 380153-379377 |
| WP_001105023 | tryptophan synthase trpB | 381350-380157 |
| WP_000536712 | tryptophan synthase trpC | 382719-381958 |
| -Zeatin | ||
| WP_000504938 | MiaA | 3319276-3320229 |
| Biofilm | ||
| -Spermidine | ||
| WP_000424696 | spermidine synthase | 1716349-1717176 |
| EEK42871 | S-adenosylmethionine decarboxylase | 2459113-2459430 |
| WP_001209831 | agmatinase | 1717394-1718266 |
| Chitinase | ||
| WP_000837164 | chitinase | 1149777-1151819 |
| WP_000932466 | chitinase | 3309435-3308353 |
| Serine protease | ||
| WP_001089044 | serine protease | 4854324-4853374 |
| WP_000747582 | serine protease | 335901-336728 |
| WP_000008058 | serine protease | 1616343-1617518 |
| WP_000728874 | subtilisin-like serine proteases | 2178374-2174151 |
| WP_000754169 | subtilisin-like serine proteases | 2711340-2708572 |
| WP_000689206 | subtilisin-like serine proteases | 3274577-3276418 |
| WP_000820235 | subtilisin-like serine proteases | 4423951-4419710 |
| WP_000790939 | subtilisin-like serine proteases | 4545913-4547106 |
| WP_000542636 | trypsin-like serine proteases | 3435940-3437181 |
| WP_041184482 | trypsin-like serine proteases | 1930012-1931196 |
| Phosphate solubilizing | ||
| WP_080120806 | metallophosphoesterase | 768312-765853 |
| WP_000356445 | phosphodiesterases | 1142793-1144106 |
| WP_000714924 | alkaline phosphatase, PhoA | 2717644-2719029 |
| WP_000067230 | alkaline phosphatase, PhoA | 3951628-3953313 |
| acc. No. | Gene | FC1 | FC2 | acc. No. | Gene | FC1 | FC2 |
|---|---|---|---|---|---|---|---|
| defense metabolites | |||||||
| -lignin | |||||||
| AT1G30700 | ATBBE8 | 2.4 | 4.4 | AT1G30720 | ATBBE10 | 4.1 | 5.6 |
| AT1G30730 | ATBBE11 | 4.2 | 5.4 | AT1G26420 | ATBBE7 | 2.1 | 3.4 |
| AT1G26380 | ATBBE3 | 2.2 | 5.0 | AT1G26390 | ATBBE4 | 5.1 | 10.9 |
| AT1G26410 | ATBBE6 | 4.8 | 18.2 | AT1G67980 | CCOAMT | 2.0 | 5.7 |
| -terpenoids | |||||||
| AT1G61120 | TPS4 | 2.7 | 3.9 | AT5G42600 | MRN1 | 8.3 | 31.1 |
| AT5G48010 | THAS1 | 2.0 | 9.1 | ||||
| -alkaloids | |||||||
| AT2G30750 | CYP71A12 | 3.0 | 4.4 | AT2G29350 | SAG13 | 4.6 | 6.6 |
| -glucosinolates | |||||||
| AT1G21100 | IGMT1 | 2.2 | 2.4 | ||||
| AT1G21110 | IGMT3 | 2.8 | 2.8 | AT1G21120 | IGMT2 | 2.3 | 2.4 |
| AT1G76790 | IGMT5 | 2.0 | 2.2 | AT5G57220 | CYP81F2 | 2.9 | 2.3 |
| - phytoalexin | |||||||
| AT4G31970 | CYP82C2 | 2.7 | 9.1 | ||||
| -osmolytes | |||||||
| AT2G18700 | ATTPS11 | 2.2 | 1.7 | AT2G39800 | P5CS1 | 3.1 | 2.8 |
| -lipid signal | |||||||
| AT1G54020 | GLIP | 4.6 | 9.9 | AT5G40990 | GLIP1 | 4.6 | 27.5 |
| -pest resistance | |||||||
| AT5G14180 | MPL1 | 2.2 | 3.9 | AT3G28740 | CYP81D11 | 5.2 | 4.3 |
| AT2G39030 | NATA1 | 4.0 | 4.9 | ||||
| PR proteins | |||||||
| -PR-6 | |||||||
| AT5G43570 | PR-6 | 14.2 | 20.1 | AT1G17860 | ATKTI5 | 2.0 | 2.6 |
| AT1G73260 | KTI1 | 7.3 | 9.1 | AT2G43510 | TI1 | 3.8 | 6.7 |
| AT5G43580 | UPI | 4.2 | 7.4 | ||||
| -PR12 | |||||||
| AT3G59930 | DEFL | 3.8 | 3.0 | AT5G44420 | PDF1.2 | 6.0 | 4.6 |
| AT5G44430 | PDF1.2C | 3.8 | 3.9 | AT1G19610 | PDF1.4 | 3.6 | 10.1 |
| AT2G26010 | PDF1.3 | 6.1 | 4.2 | ||||
| -PR3 | |||||||
| AT5G24090 | CHIA | 2.0 | 3.2 | AT2G43570 | CHI | 2.2 | 2.0 |
| AT2G43620 | CHI | 4.0 | 2.2 | AT2G43590 | PR-3 like | 2.9 | 2.0 |
| -PR2 | |||||||
| AT3G57260 | PR2 | 2.9 | 2.0 | AT4G16260 | PR2 | 2.4 | 2.0 |
| -PR13 | |||||||
| AT1G72260 | THI2.1 | 3.2 | 10.9 | ||||
| -PR5 | |||||||
| AT4G11650 | OSM34 | 5.2 | 5.9 | ||||
| ROS scavenging | |||||||
| AT1G74590 | GSTU10 | 2.4 | 6.8 | AT4G04810 | MSRB4 | 2.0 | 3.5 |
| AT4G21830 | MSRB7 | 2.2 | 3.4 | AT1G80160 | GLY17 | 3.5 | 2.9 |
| AT5G64120 | PER71 | 2.6 | 3.1 | AT2G18150 | PER | 2.2 | 2.0 |
| AT5G19880 | PER | 6.6 | 31.3 | AT3G49120 | PERX34 | 2.0 | 2.2 |
| AT1G65970 | PRXIIC | 2.1 | 3.4 | ||||
| Phytohormones | |||||||
| AT3G44300 | NIT2 | 7.9 | 11.1 | AT3G29250 | SDR4 | 3.9 | 6.1 |
| AT3G01420 | DOX1 | 2.4 | 4.1 | AT1G53903 | LOX | 2.9 | 2.7 |
| AT3G11480 | BSMT1 | 4.7 | 6.4 | AT1G15550 | GA3OX1 | 3.0 | 3.2 |
| AT5G51810 | GA20OX2 | 2.2 | 3.6 | ||||
| Transcription factors | |||||||
| AT3G02040 | SRG3 | 2.0 | 2.0 | AT5G24110 | WRKY30 | 4.0 | 2.1 |
| AT1G18860 | WRKY61 | 3.9 | 5.3 | AT4G22070 | WRKY31 | 3.2 | 6.0 |
| AT1G29860 | WRKY71 | 3.3 | 5.7 | AT1G73410 | MYB54 | 2.8 | 4.3 |
Disclaimer/Publisher’s Note: The statements, opinions and data contained in all publications are solely those of the individual author(s) and contributor(s) and not of MDPI and/or the editor(s). MDPI and/or the editor(s) disclaim responsibility for any injury to people or property resulting from any ideas, methods, instructions or products referred to in the content. |
© 2023 by the authors. Licensee MDPI, Basel, Switzerland. This article is an open access article distributed under the terms and conditions of the Creative Commons Attribution (CC BY) license (https://creativecommons.org/licenses/by/4.0/).
Share and Cite
Tsai, S.-H.; Hsiao, Y.-C.; Chang, P.E.; Kuo, C.-E.; Lai, M.-C.; Chuang, H.-w. Exploring the Biologically Active Metabolites Produced by Bacillus cereus for Plant Growth Promotion, Heat Stress Tolerance, and Resistance to Bacterial Soft Rot in Arabidopsis. Metabolites 2023, 13, 676. https://doi.org/10.3390/metabo13050676
Tsai S-H, Hsiao Y-C, Chang PE, Kuo C-E, Lai M-C, Chuang H-w. Exploring the Biologically Active Metabolites Produced by Bacillus cereus for Plant Growth Promotion, Heat Stress Tolerance, and Resistance to Bacterial Soft Rot in Arabidopsis. Metabolites. 2023; 13(5):676. https://doi.org/10.3390/metabo13050676
Chicago/Turabian StyleTsai, Sih-Huei, Yi-Chun Hsiao, Peter E. Chang, Chen-En Kuo, Mei-Chun Lai, and Huey-wen Chuang. 2023. "Exploring the Biologically Active Metabolites Produced by Bacillus cereus for Plant Growth Promotion, Heat Stress Tolerance, and Resistance to Bacterial Soft Rot in Arabidopsis" Metabolites 13, no. 5: 676. https://doi.org/10.3390/metabo13050676
APA StyleTsai, S.-H., Hsiao, Y.-C., Chang, P. E., Kuo, C.-E., Lai, M.-C., & Chuang, H.-w. (2023). Exploring the Biologically Active Metabolites Produced by Bacillus cereus for Plant Growth Promotion, Heat Stress Tolerance, and Resistance to Bacterial Soft Rot in Arabidopsis. Metabolites, 13(5), 676. https://doi.org/10.3390/metabo13050676
